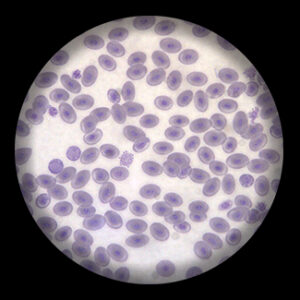
สไลด์ถาวร เซลล์เม็ดเลือดกบ
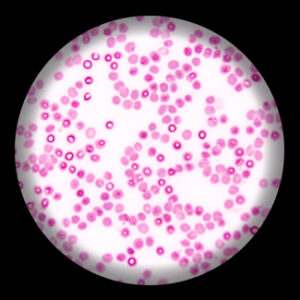
สไลด์ถาวร เซลล์เม็ดเลือดคน

สไลด์ถาวร
คัดกรอง
Showing 251–275 of 286 results
-
สไลด์ถาวร เซลล์รังไข่กระต่าย
-
สไลด์ถาวร เซลล์สาหร่ายหางกระรอก
-
สไลด์ถาวร เซลล์อสุจิคน
-
สไลด์ถาวร เซลล์เนื้อเยื่อใบเลี้ยงข้าว
-
สไลด์ถาวร เซลล์เม็ดเลือดกบ
-
สไลด์ถาวร เซลล์เม็ดเลือดคน
-
สไลด์ถาวร เซลล์เยื่อบุข้างแก้ม
-
สไลด์ถาวร เซลล์เยื่อหอม
-
สไลด์ถาวร เนื้อเยื่อพืช คลอเรงไคมา
-
สไลด์ถาวร เนื้อเยื่อพืช พาเรงไคมา
-
สไลด์ถาวร เนื้อเยื่อพืช สเคลเรงไคมา
-
สไลด์ถาวร เฟิร์น
-
สไลด์ถาวร แบคทีเรีย
-
สไลด์ถาวร แบคทีเรีย Actinomycetes
-
สไลด์ถาวร แบคทีเรีย Coccus Bacillus
-
สไลด์ถาวร แบคทีเรีย Staphylococcus Aureus
-
สไลด์ถาวร แบคทีเรีย แบบรูปกลม
-
สไลด์ถาวร แบคทีเรีย แบบรูปท่อน
-
สไลด์ถาวร แบคทีเรีย แบบรูปเกลียว
-
สไลด์ถาวร แสดงการงอกของละอองเรณู
-
สไลด์ถาวร แสดงลักษณะของละอองเรณูแบบต่างๆ
-
สไลด์ถาวร แสดงลักษณะรังไข่
-
สไลด์ถาวร โครงสร้างรังไข่ตัดตามยาว
-
สไลด์ถาวร โปโตซัว วอลติเซลลา
-
สไลด์ถาวร โปโตซัว โอบีเลีย